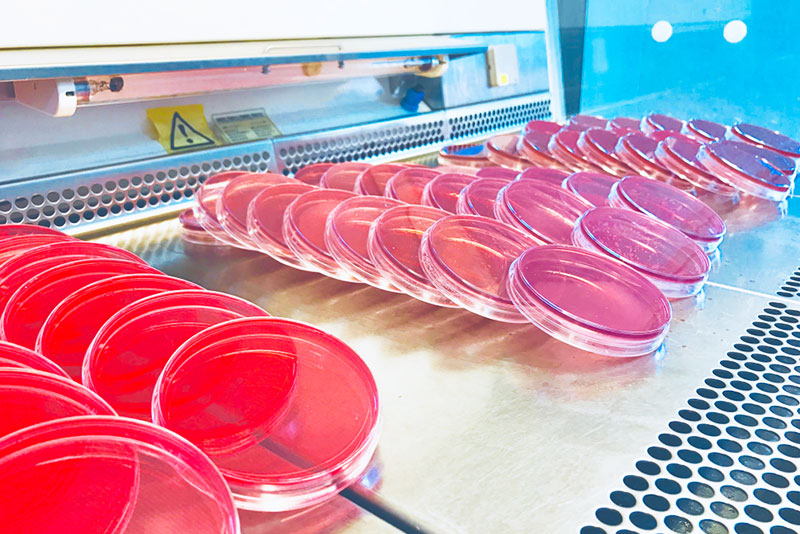
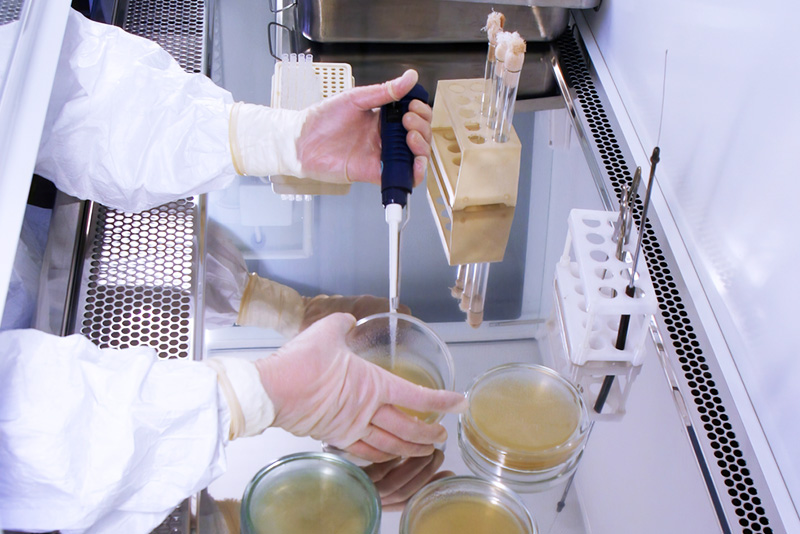
An Toàn Sinh Học Là Gì? Vai Trò, Các Cấp Độ, Quy Định Cần Nắm Về An Toàn Sinh Học

An Toàn Sinh Học Là Gì? Vai Trò, Các Cấp Độ, Quy Định Cần Nắm Về An Toàn Sinh Học
Trong mọi quy trình nghiên cứu, xét nghiệm lâm sàng đến chăn nuôi và công nghệ sinh học ngày nay, an toàn sinh học (Biosafety) đều được xem như tiêu chuẩn cốt lõi. Hiểu rõ an toàn sinh học là gì, vai trò, các cấp độ cũng như quy định cần nắm về an toàn sinh học không chỉ giúp bảo vệ nhân viên phòng thí nghiệm mà còn ngăn ngừa hiểm họa phát tán mầm bệnh ra cộng đồng. Bài viết dưới đây của Thiết bị Hiệp Phát sẽ giải thích toàn diện về khái niệm an toàn sinh học (Biosafety), 4 cấp độ BSL theo tiêu chuẩn WHO & CDC, những quy định pháp lý tại Việt Nam và cùng ứng dụng thực tiễn trong phòng thí nghiệm.
An toàn sinh học là gì?
An toàn sinh học (tiếng Anh: Biosafety) là tổng hợp các nguyên tắc, chính sách và quy trình được thiết kế nhằm ngăn ngừa việc vô tình tiếp xúc với các tác nhân sinh học nguy hiểm như vi khuẩn, virus, nấm, ký sinh trùng và chất độc sinh học — qua đó bảo vệ sức khỏe con người, động vật và môi trường.
ATSH bao gồm các cấp độ phòng thí nghiệm (BSL 1-4), được sử dụng rộng rãi trong nhiều lĩnh vực khác nhau từ phòng xét nghiệm y tế, nghiên cứu vi sinh đến chăn nuôi và công nghệ sinh học. Điểm chung của tất cả định nghĩa là kiểm soát nguy cơ sinh học để giảm thiểu tác hại.
Theo Tổ chức Y tế Thế giới (WHO), an toàn sinh học ban đầu được hiểu là tập hợp các biện pháp phòng ngừa nhằm giảm nguy cơ lây truyền bệnh truyền nhiễm ở cây trồng, vật nuôi và các sinh vật biến đổi gen. Ngày nay, phạm vi khái niệm này đã mở rộng đáng kể, bao gồm cả quản lý phòng thí nghiệm y sinh, y tế công cộng và an ninh quốc gia.

Vai trò của an toàn sinh học
Việc tuân thủ nghiêm ngặt các nguyên tắc ATSH giúp:
- Bảo vệ nhân viên: Giảm thiểu nguy cơ nhiễm bệnh nghề nghiệp do tai nạn, kim đâm hoặc hít phải khí dung (aerosol).
- Bảo vệ môi trường: Đảm bảo rác thải y tế và khí thải được xử lý triệt để, không làm ô nhiễm nguồn nước và không khí.
- Đảm bảo tính chính xác của nghiên cứu: Ngăn chặn nhiễm chéo giữa các mẫu bệnh phẩm.
Các cấp độ an toàn sinh học (BSL-1 đến BSL-4)

Tổ chức Y tế Thế giới (WHO) và Trung tâm Kiểm soát và Phòng ngừa Dịch bệnh (CDC) phân loại phòng xét nghiệm thành 4 cấp độ (Biosafety Levels – BSL), tăng dần theo mức độ nguy hiểm của tác nhân vi sinh vật. Dưới đây là thông tin chi tiết từng cấp độ:
Cấp độ 1 (BSL-1): Tác nhân ít nguy hiểm, nguy cơ tối thiểu
Áp dụng cho các loại vi sinh vật ít có khả năng gây bệnh cho người trưởng thành khỏe mạnh. Nhân viên chỉ cần tuân thủ các quy tắc vệ sinh cơ bản, mặc áo blouse và đeo găng tay khi cần thiết.
Cấp độ 2 (BSL-2): Tác nhân gây bệnh vừa phải cho con người
Dành cho các tác nhân có khả năng gây bệnh thông qua tiếp xúc hoặc vết thương hở nhưng khó lây qua đường hô hấp.
- Yêu cầu: Phải có biển báo nguy hiểm sinh học, nồi hấp tiệt trùng và tủ an toàn sinh học cấp 2 để thao tác với các mẫu có nguy cơ tạo khí dung.
Cấp độ 3 (BSL-3): Tác nhân gây bệnh nặng, lây qua đường hô hấp
Sử dụng cho các vi sinh vật có thể gây bệnh nghiêm trọng hoặc tử vong thông qua lây truyền đường hô hấp.
- Thiết kế: Phòng thí nghiệm phải được thiết kế biệt lập, có hệ thống thông gió một chiều (áp suất âm) để không khí không thoát ngược ra ngoài hành lang.
Cấp độ 4 (BSL-4): Tác nhân cực kỳ nguy hiểm, gây tử vong cao
Đây là cấp độ cao nhất dành cho các tác nhân cực kỳ nguy hiểm, chưa có vaccine hoặc phương pháp điều trị hiệu quả, đòi hỏi cách ly tuyệt đối
- Vận hành: Nhân viên phải thay đồ hoàn toàn trước khi vào và tắm khử độc khi ra ngoài. Toàn bộ thao tác thực hiện trong tủ ATSH cấp III hoặc mặc bộ đồ bảo hộ có áp suất dương.
Việc tuân thủ an toàn sinh học là bắt buộc, đặc biệt tại các phòng xét nghiệm và cơ sở nghiên cứu để giảm thiểu rủi ro sinh học.
Bảng so sánh nhanh 4 cấp độ ATSH
| Cấp độ | Tác nhân gây bệnh | Mức độ rủi ro | Thiết bị yêu cầu |
| BSL-1 | E.coli không gây bệnh, B.subtilis | Thấp (Cá nhân & Cộng đồng) | Bàn thí nghiệm hở, bồn rửa tay |
| BSL-2 | Viêm gan B, C, HIV, Cúm A | Trung bình (Cá nhân), Thấp (Cộng đồng) | Tủ an toàn sinh học cấp 2, Nồi hấp tiệt trùng |
| BSL-3 | Vi khuẩn Lao, SARS-CoV, Than | Cao (Cá nhân), Trung bình (Cộng đồng) | Áp suất âm, lọc khí HEPA, lối vào kép |
| BSL-4 | Ebola, Virus Marburg | Rất cao (Cá nhân & Cộng đồng) | Bộ đồ bảo hộ kín, hệ thống oxy riêng biệt |
Ba Nguyên Lý Cốt Lõi Của An Toàn Sinh Học
Theo WHO và CDC, hệ thống an toàn sinh học vận hành dựa trên ba lớp rào cản bảo vệ kết hợp với nhau:
Thực hành kỹ thuật tốt (GMT)
Đây là nền tảng quan trọng nhất — bao gồm kỹ năng và ý thức của nhân viên. Thực hành vi sinh tốt (Good Microbiological Techniques) bao gồm:
- Không hút pipet bằng miệng
- Rửa tay thường xuyên
- Khử trùng bề mặt làm việc
- Xử lý đúng quy trình vật liệu sắc nhọn và lây nhiễm
- Không ăn/uống trong phòng thí nghiệm
Thiết bị an toàn (Rào cản sơ cấp)
Thiết bị an toàn là rào cản đầu tiên bảo vệ nhân viên khỏi tiếp xúc trực tiếp với tác nhân lây nhiễm. Thiết bị chính bao gồm:
- Tủ an toàn sinh học (BSC): Ngăn chặn khí dung lây nhiễm phát tán ra ngoài khu vực làm việc

- Trang bị bảo hộ cá nhân (PPE): Áo choàng, găng tay, khẩu trang, kính bảo hộ, bộ quần áo áp suất dương (cấp cao)
- Nồi hấp tiệt trùng (Autoclave): Khử nhiễm vật liệu và chất thải sinh học trước khi thải bỏ

Cơ sở tiện nghi phòng thí nghiệm (Rào cản thứ cấp)
Cơ sở vật chất là rào cản thứ hai — bảo vệ môi trường bên ngoài và những người không trực tiếp làm việc với tác nhân lây nhiễm. Yêu cầu thiết kế bao gồm:
- Tách biệt khu vực làm việc với khu hành chính
- Hệ thống thông gió và lọc khí riêng biệt
- Cửa chịu áp và hệ thống xử lý nước thải đặc biệt ở cấp độ cao
Quy định pháp lý về An toàn sinh học tại Việt Nam
Hệ thống an toàn sinh học tại Việt Nam được điều chỉnh bởi nhiều văn bản pháp luật quan trọng:
Các văn bản pháp lý chính về ATSH tại Việt Nam
- Nghị định 103/2016/NĐ-CP: Quy định điều kiện bảo đảm an toàn sinh học tại phòng xét nghiệm; phân loại vi sinh vật và cơ sở xét nghiệm theo 4 cấp độ ATSH; thủ tục cấp Giấy chứng nhận ATSH.
- Thông tư 37/2017/TT-BYT (Bộ Y tế):Hướng dẫn thực hành bảo đảm an toàn sinh học trong phòng xét nghiệm; quy định chi tiết yêu cầu về cơ sở vật chất, thiết bị và nhân sự cho từng cấp độ.
- Thông tư 41/2016/TT-BYT:Ban hành danh mục vi sinh vật gây bệnh truyền nhiễm theo nhóm nguy cơ và cấp độ an toàn sinh học phù hợp kỹ thuật xét nghiệm.
- Luật Phòng, chống bệnh truyền nhiễm 2007:Nền tảng pháp lý cho quản lý các tác nhân gây bệnh truyền nhiễm và an toàn sinh học y tế cộng đồng
Theo Nghị định 103/2016/NĐ-CP các cơ sở xét nghiệm phải tuân thủ quy định về bảo đảm an toàn sinh học tại phòng xét nghiệm. Nghị định quy định rõ:
- Cơ sở vật chất: Tiêu chuẩn về diện tích, vật liệu bề mặt chống thấm, hệ thống xử lý nước thải.
- Trang thiết bị: Quy chuẩn về tủ an toàn sinh học và hiệu chuẩn định kỳ.
- Nhân sự: Phải được đào tạo và có chứng chỉ tập huấn về an toàn sinh học.
- Hồ sơ pháp lý: Phòng xét nghiệm cấp III và IV phải được Bộ Y tế cấp Giấy chứng nhận đạt tiêu chuẩn ATSH.
Trình tự cấp Giấy chứng nhận ATSH
Để được chứng nhận cấp độ an toàn sinh học, các cơ sở cần thực hiện quy trình gồm 5 bước:
- Bước 1 – Xác định cấp độ ATSH phù hợp dựa trên loại tác nhân sinh học và kỹ thuật xét nghiệm theo quy định của Bộ Y tế.
- Bước 2 – Đầu tư cơ sở vật chất và trang thiết bị đáp ứng đúng tiêu chuẩn của cấp độ đã xác định.
- Bước 3 – Đào tạo nhân sự theo yêu cầu an toàn sinh học tương ứng.
- Bước 4 – Lập và nộp hồ sơ đề nghị bao gồm: đơn đề nghị, giấy phép hoạt động, bản mô tả hệ thống quản lý ATSH, tài liệu chứng minh đáp ứng yêu cầu.
- Bước 5 – Thẩm định và cấp Giấy chứng nhận bởi cơ quan có thẩm quyền (Sở Y tế hoặc Bộ Y tế tùy cấp độ). Sở Y tế định kỳ tối thiểu 3 năm/lần kiểm tra, thanh tra lại.
Ứng Dụng An Toàn Sinh Học Trong Thực Tiễn

An toàn sinh học không chỉ giới hạn trong phòng thí nghiệm mà được áp dụng rộng rãi trong nhiều lĩnh vực:
- Y tế lâm sàng: Kiểm soát nhiễm khuẩn bệnh viện, quản lý bệnh phẩm, liệu pháp gen và các sản phẩm sinh học y tế.
- Nông nghiệp: Kiểm soát dịch hại, quản lý sinh vật biến đổi gen (GMO), phòng chống dịch bệnh gia súc gia cầm.
- Nghiên cứu sinh học: Nghiên cứu vi sinh, phát triển vaccine và thuốc, xét nghiệm lâm sàng tại các phòng thí nghiệm BSL 1–3.
- Công nghệ sinh học: Sản xuất vaccine, kháng sinh, enzyme và các chế phẩm sinh học trong quy mô công nghiệp.
- Môi trường: Giám sát ô nhiễm sinh học nguồn nước, kiểm soát sinh vật ngoại lai xâm lấn trong hệ sinh thái.
- Nghiên cứu vũ trụ: NASA và ESA áp dụng tiêu chuẩn ATSH đặc biệt để ngăn ngừa ô nhiễm sinh học giữa Trái đất và không gian.
Các câu hỏi thường gặp về an toàn sinh học (FAQ)
Câu 1: An toàn sinh học cấp 2 (BSL-2) khác BSL-1 như thế nào?
Trả lời: BSL-2 được áp dụng khi làm việc với các tác nhân có khả năng gây bệnh ở người (như HIV, Hepatitis B/C). Điểm khác biệt chính so với BSL-1 là: nhân viên bắt buộc được đào tạo chuyên biệt; phòng thí nghiệm phải hạn chế tiếp cận trong khi làm việc; cần sử dụng tủ an toàn sinh học khi có nguy cơ tạo khí dung hoặc giọt bắn; có hệ thống giám sát sức khỏe nhân viên và tiêm chủng phòng bệnh.
Câu 2: Tủ an toàn sinh học có giống tủ cấy vi sinh không?
Trả lời: Không. Tủ cấy vi sinh (Laminar Flow) chỉ bảo vệ mẫu vật. Tủ an toàn sinh học (BSC) được thiết kế để bảo vệ đồng thời cả nhân viên, mẫu vật và môi trường.
Câu 3: Tủ an toàn sinh học có mấy loại?
Trả lời: Tủ an toàn sinh học (Biological Safety Cabinet – BSC) là thiết bị làm việc trong môi trường kiểm soát không khí, giúp bảo vệ nhân viên, sản phẩm và môi trường khỏi khí dung lây nhiễm. Có 3 loại chính: Loại I (bảo vệ nhân viên và môi trường, không bảo vệ sản phẩm), Loại II (bảo vệ cả 3 chiều – phổ biến nhất tại các phòng xét nghiệm BSL-2 và BSL-3), và Loại III (tủ kín hoàn toàn với tay thao tác cao su – dùng cho BSL-3 và BSL-4).
Quý khách hàng có thể tham khảo thêm dòng Tủ An Toàn Sinh Học Cấp 2 A2 Jeiotech JB Series của Thiết bị Hiệp Phát

Câu 4: Việt Nam có phòng thí nghiệm BSL-4 không?
Trả lời: Tính đến thời điểm hiện tại, Việt Nam chưa có phòng thí nghiệm BSL-4 đạt tiêu chuẩn đầy đủ và hoạt động chính thức. Các nghiên cứu yêu cầu cấp độ BSL-4 phải được thực hiện tại các cơ sở quốc tế được công nhận hoặc trong điều kiện hợp tác được phê duyệt đặc biệt. Các phòng thí nghiệm BSL-3 cao cấp tại Việt Nam đang được đầu tư nâng cấp trong khuôn khổ các chương trình y tế quốc gia.
Câu 5: Ai cấp giấy chứng nhận ATSH cho phòng thí nghiệm?
Trả lời: Theo Nghị định 103/2016/NĐ-CP: Bộ Y tế cấp Giấy chứng nhận cho phòng xét nghiệm an toàn sinh học cấp III và cấp IV; Sở Y tế cấp tỉnh cấp cho cơ sở xét nghiệm an toàn sinh học cấp I và cấp II. Sở Y tế định kỳ tối thiểu 3 năm/lần kiểm tra, thanh tra lại các cơ sở đã được cấp giấy chứng nhận.
Câu 6: Biểu tượng an toàn sinh học trông như thế nào?
Biểu tượng an toàn sinh học quốc tế có hình dạng ba vòng tròn lồng vào nhau theo kiểu xoắn ốc đặc trưng (được thiết kế năm 1966 bởi Dow Chemical). Biển báo ATSH tại phòng thí nghiệm thường có màu nền vàng, chữ và biểu tượng màu đen, kèm theo thông tin cấp độ nguy hiểm, tên tác nhân sinh học liên quan và hướng dẫn tiếp cận. Đây là yêu cầu bắt buộc theo tiêu chuẩn quốc tế và quy định Việt Nam.

Câu 7: Phân biệt An Toàn Sinh Học vs. An Ninh Sinh Học
Trả lời: Nhiều người nhầm lẫn giữa hai khái niệm này. Dưới đây là bảng so sánh chi tiết:
| Tiêu chí | An Toàn Sinh Học (Biosafety) | An Ninh Sinh Học (Biosecurity) |
| Mục tiêu | Ngăn ngừa phơi nhiễm vô tình | Ngăn ngừa sử dụng cố ý sai mục đích |
| Đối tượng mối đe dọa | Tai nạn phòng thí nghiệm, rò rỉ | Khủng bố sinh học, trộm cắp mầm bệnh |
| Biện pháp chính | Thiết bị bảo hộ, quy trình xét nghiệm, cơ sở vật chất | Kiểm soát tiếp cận, giám sát hàng tồn kho, điều tra nhân sự |
| Cơ quan quản lý | WHO, CDC, Bộ Y tế | Chính phủ, An ninh quốc gia, Tình báo |
| Quy định Việt Nam | Nghị định 103/2016, Thông tư 37/2017 | Luật An ninh quốc gia, Nghị định kiểm soát vũ khí sinh học |
Hai lĩnh vực này bổ sung và tăng cường lẫn nhau. Một hệ thống quản lý rủi ro sinh học toàn diện cần kết hợp cả an toàn sinh học lẫn an ninh sinh học.
Kết luận
Việc nắm vững kiến thức về an toàn sinh học là yêu cầu bắt buộc đối với bất kỳ ai làm việc trong ngành y tế và nghiên cứu. Đầu tư vào hạ tầng đạt chuẩn và đào tạo nhân sự chính là rào chắn vững chắc nhất để bảo vệ sức khỏe con người trước những nguy cơ sinh học tiềm tàng. Công ty TNHH Thiết bị Hiệp Phát là nhà phân phối các dòng thiết bị chuyên dụng, đáp ứng yêu cầu ATSH trong phòng thí nghiệm. Các dòng thiết bị do Hiệp Phát cung cấp bao gồm: Tủ an toàn sinh học cấp 2, nồi hấp tiệt trùng từ các hãng sản xuất Jeiotech (Hàn Quốc)và ALP (Nhật Bản), đảm bảo chất lượng và uy tín. Nếu quý khách hàng đang có nhu cầu tìm mua các dòng thiết bị phòng thí nghiệm đáp ứng quy định an toàn sinh học BSL-2 tại Việt Nam, đừng ngần ngại liên hệ với chúng tôi qua Sđt: 0919.537.653 – Mr. Tú hoặc Email: sales5@thietbihiepphat.com để được hỗ trợ kịp thời.

Để lại thắc mắc, chúng tôi sẽ giải đáp ngay cho bạn



 VN
VN














